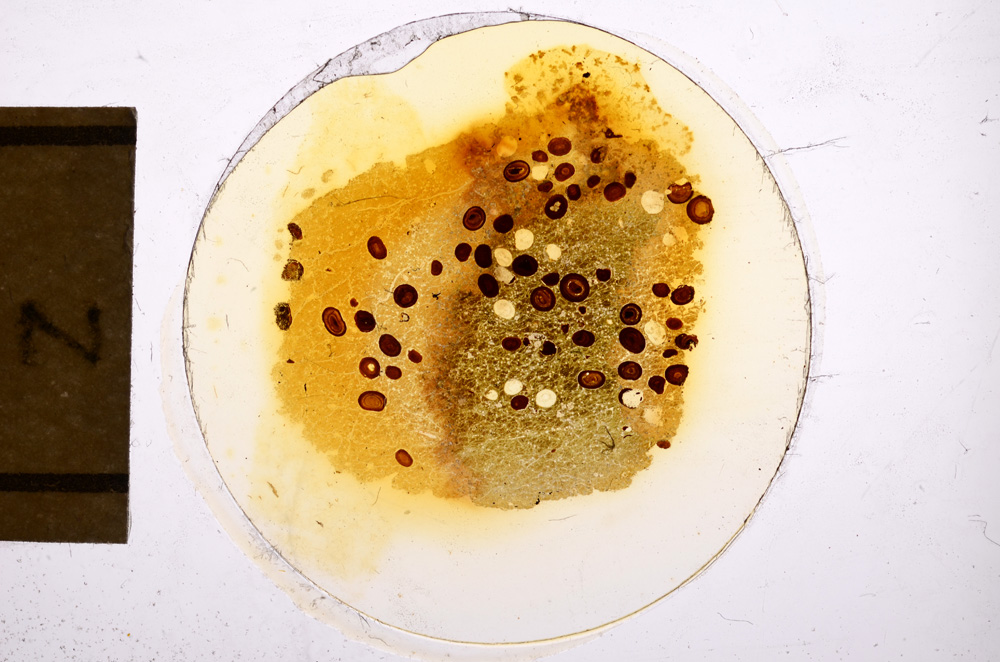
Plane Polarized, E12719

| Sample number |
E12719 |
| Sample Donor |
Hallimond,Doctor |
| Rock name |
'Original entry: Ironstone-Limonite Ooliths In Chamosite-Siderite Matrix' |
| Stratigraphy |
Not entered |
| Comments |
Spec. not kept see col. List No8 Dr Hallimond Fig. Spec. rep. No6 lxxix Pl vii fig. 36 |
| Locality details |
Westbury |
| 50k map sheet |
Frome (281)
View images in GeoScenic related to 'Frome'
View the geology near 'Frome'
|
| Map reference |
ST 87 51 |
| Year collected |
Not entered |
| Bore name |
Not applicable |
| Confidentiality |
No restrictions |
Petrological thin sections
Links to high resolution images
Transition from XPL to PPL light
E12719